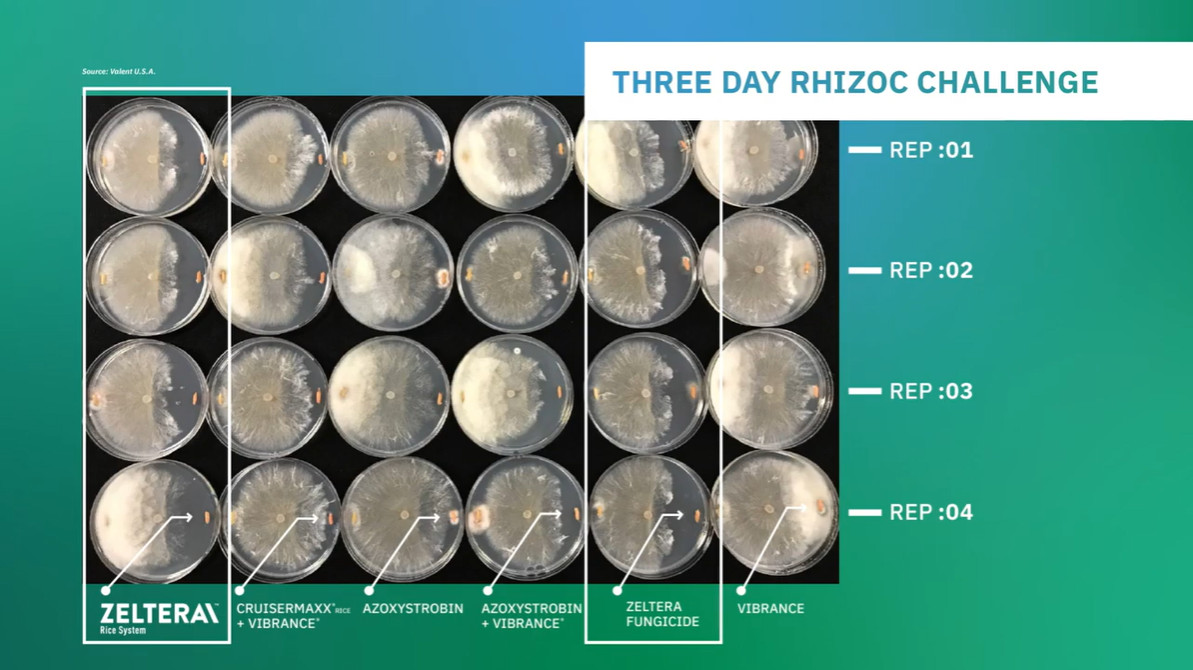

Zeltera® Rice System combines multiple fungicide modes of action and a powerful insecticide for above and below ground rice seed protection. With technology for advanced protection from Rhizoctonia, Zeltera Rice System shields plant roots to deliver strong early- and late-season stand establishment and plant vigor protecting yield. In addition to a powerful fungicide, Zeltera Rice System brings proven early-season protection against a wide spectrum of insect pests.
- Excellent, Long-lasting Control of Rhizoctonia solani, Including Strobilurin-resistant Strains
- Preventative and Systemic Activity to Protect Against Seed Decay, Seedling Blight and Damping Off
- Protects Against a Wide Spectrum of Pests Including Grape Colaspis, Rice Water Weevil and Chinch Bug
- Offers Improved Root Health and Increased Plant Stand
- Offers Smooth Flowability in the Seed Treater
Problems/Uses*
- Blackleg
- Rhizoctonia Solani Seedling Blight
- Rhizoctonia Solani Damping Off
- Rhizoctonia Solani Seed Decay
- Barley Loose Smut
- Wheat Loose Smut
- Sudden Death Syndrome
*Each crop and use may not be registered in every state. Always read and follow label instructions.
Key Crops*
- Barley
- Adzuki Bean
- Asparagus Bean
- Broad Bean
- Chinese Long Bean
- Fava Bean
- Field Bean
- Garbanzo Bean
- Hyacinth Bean
- Jack Bean
- Kidney Bean
- Lablab Bean
- Lima Bean
- Lupin Bean
- Moth Bean
- Mung Bean
- Navy Bean
- Phaseolus Bean
- Pinto Bean
- Rice Bean
- Runner Bean
- Snap Bean
- Sword Bean
- Tepary Bean
- Urd Bean
- Vigna Bean
- Wax Bean
- Yardlong Bean
- Sugar Beet
- Borage
- Buckwheat
- Catjang
- Chickpea
- Field Corn
- Sweet Corn
- Cowpea
- Crambe
- Cuphea
- Echium
- Flaxseed
- Gold-of-Pleasure
- Guar
- Lentil
- Lesquerella
- Lunaria
- Grain Lupin
- Sweet Lupin
- White Lupin
- White Sweet Lupin
- Meadowfoam
- Milkweed
- Pearl Millet
- Proso Millet
- Milo
- Hare's Ear Mustard
- Seed Mustard
- Oat
- Black-Eyed Pea
- Crowder Pea
- Dwarf Pea
- Edible-Podded Pea
- English Pea
- Field Pea
- Garden Pea
- Green Pea
- Pigeon Pea
- Pisum Pea
- Snow Pea
- Southern Pea
- Sugar Snap Pea
- Popcorn
- Seed Poppy
- Oil Radish
- Rapeseed
- Dry-Seeded Rice
- Rye
- Sesame
- Sorghum
- Soybean
- Sweet Rocket
- Teosinte
- Triticale
- Wheat
State Registrations
Product is registered for use in these states : Alabama, Arizona, Arkansas, Colorado, Connecticut, Delaware, Florida, Georgia, Idaho, Illinois, Indiana, Iowa, Kansas, Kentucky, Louisiana, Maine, Maryland, Massachusetts, Michigan, Minnesota, Mississippi, Missouri, Montana, Nebraska, Nevada, New Hampshire, New Jersey, New Mexico, New York, North Carolina, North Dakota, Ohio, Oklahoma, Oregon, Pennsylvania, Rhode Island, South Carolina, South Dakota, Tennessee, Texas, Utah, Vermont, Virginia, Washington, West Virginia, Wisconsin, Wyoming. Check to be sure a specific use pattern is approved in your area before use. Contact Valent or your local state agency for more information.
Sustainable Solutions Criteria – Zeltera® Rice System
Valent U.S.A. has developed a classification system that defines and identifies sustainable practices and attributes applicable to our ag product portfolio across three pillars of sustainability – People, Planet, and Productivity. This system, called Sustainable Solutions Criteria, uses specific icons that highlight these key sustainable practices and attributes for our products. Products that achieve a high sustainable criterion ranking across all three sustainable pillars are also denoted by the Sustainable Solutions Icon. Click on the icons below to learn how Zeltera® Rice System can support sustainable practices in your operations.
Always read and follow label instructions.
Check state registration prior to use.
Zeltera is a registered trademark of Sumitomo Chemical Corp.